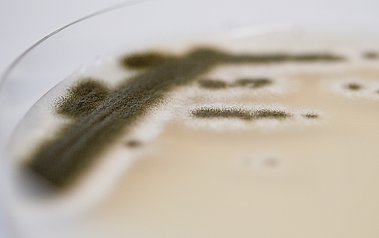

Research
Invasive fungal infections have gained increasing clinical importance over the past decades, mainly based on the fact that the numbers of patients at risk, i.e. immunocompromised individuals, have steadily risen. Among the main fungal pathogens, Aspergillus species have emerged as a severe threat for susceptible patients, as infections by this ubiquitous mould are often diagnosed late and when therapeutic options are limited. A. fumigatus is evident as the main pathogenic species among aspergilli, and current research approaches focus on fungal traits, commonly termed as the virulome, as well as host factors that promote onset and progression of aspergillosis.
Current projects of the research group focus on different aspects of the Aspergillus lifestyle, such as fungal virulence determinants for invasive aspergillosis, the pathogen-host cellular interaction, and the extant sexual cycle of A. fumigatus; moreover, methods and tools are developed and improved with the aim to enhance means of Aspergillus molecular biology:
As environmental saprobe and opportunistic pathogen, A. fumigatus strictly relies on growth at the site of infection. Among the fungal traits that support host invasion, assimilation of sulfur, biosynthesis of aromatic amino acids, extracellular proteolysis and uptake of breakdown products, purine catabolism, or fluoride export are studied on the molecular level.
Furthermore, the interaction of A. fumigatus conidia or hyphae with specific host cells, such as platelets or eosinophils, is scrutinized and the influence of fungal effectors and components on their activation is monitored. Accordingly, an impact of the major mycotoxin gliotoxin on platelet activation could be revealed. Also, a significant influence of A. fumigatus cell wall components and secreted proteases on eosinophilic granulocytes became evident.
A further research topic aims at an in-depth analysis of the bipolar mating-type system encoded on the MAT1 locus of A. fumigatus isolates and that determines fruiting body formation and ascosporogenesis. Molecular characterization of the regulatory factors had been accompanied by transcription profile analyses to reveal a strong impact of the mating-type identity on natural product formation, specifically on expression of a supercluster for the production of fumagillin and pseurotin.
To advance molecular approaches for gene targeting, recipient strains with enhanced homologous recombination, self-excisable marker modules, and fluorescent as well as bioluminescent reporter strains had been generated and validated to be made available to the fungal research community, where they have been established in several expert laboratories.